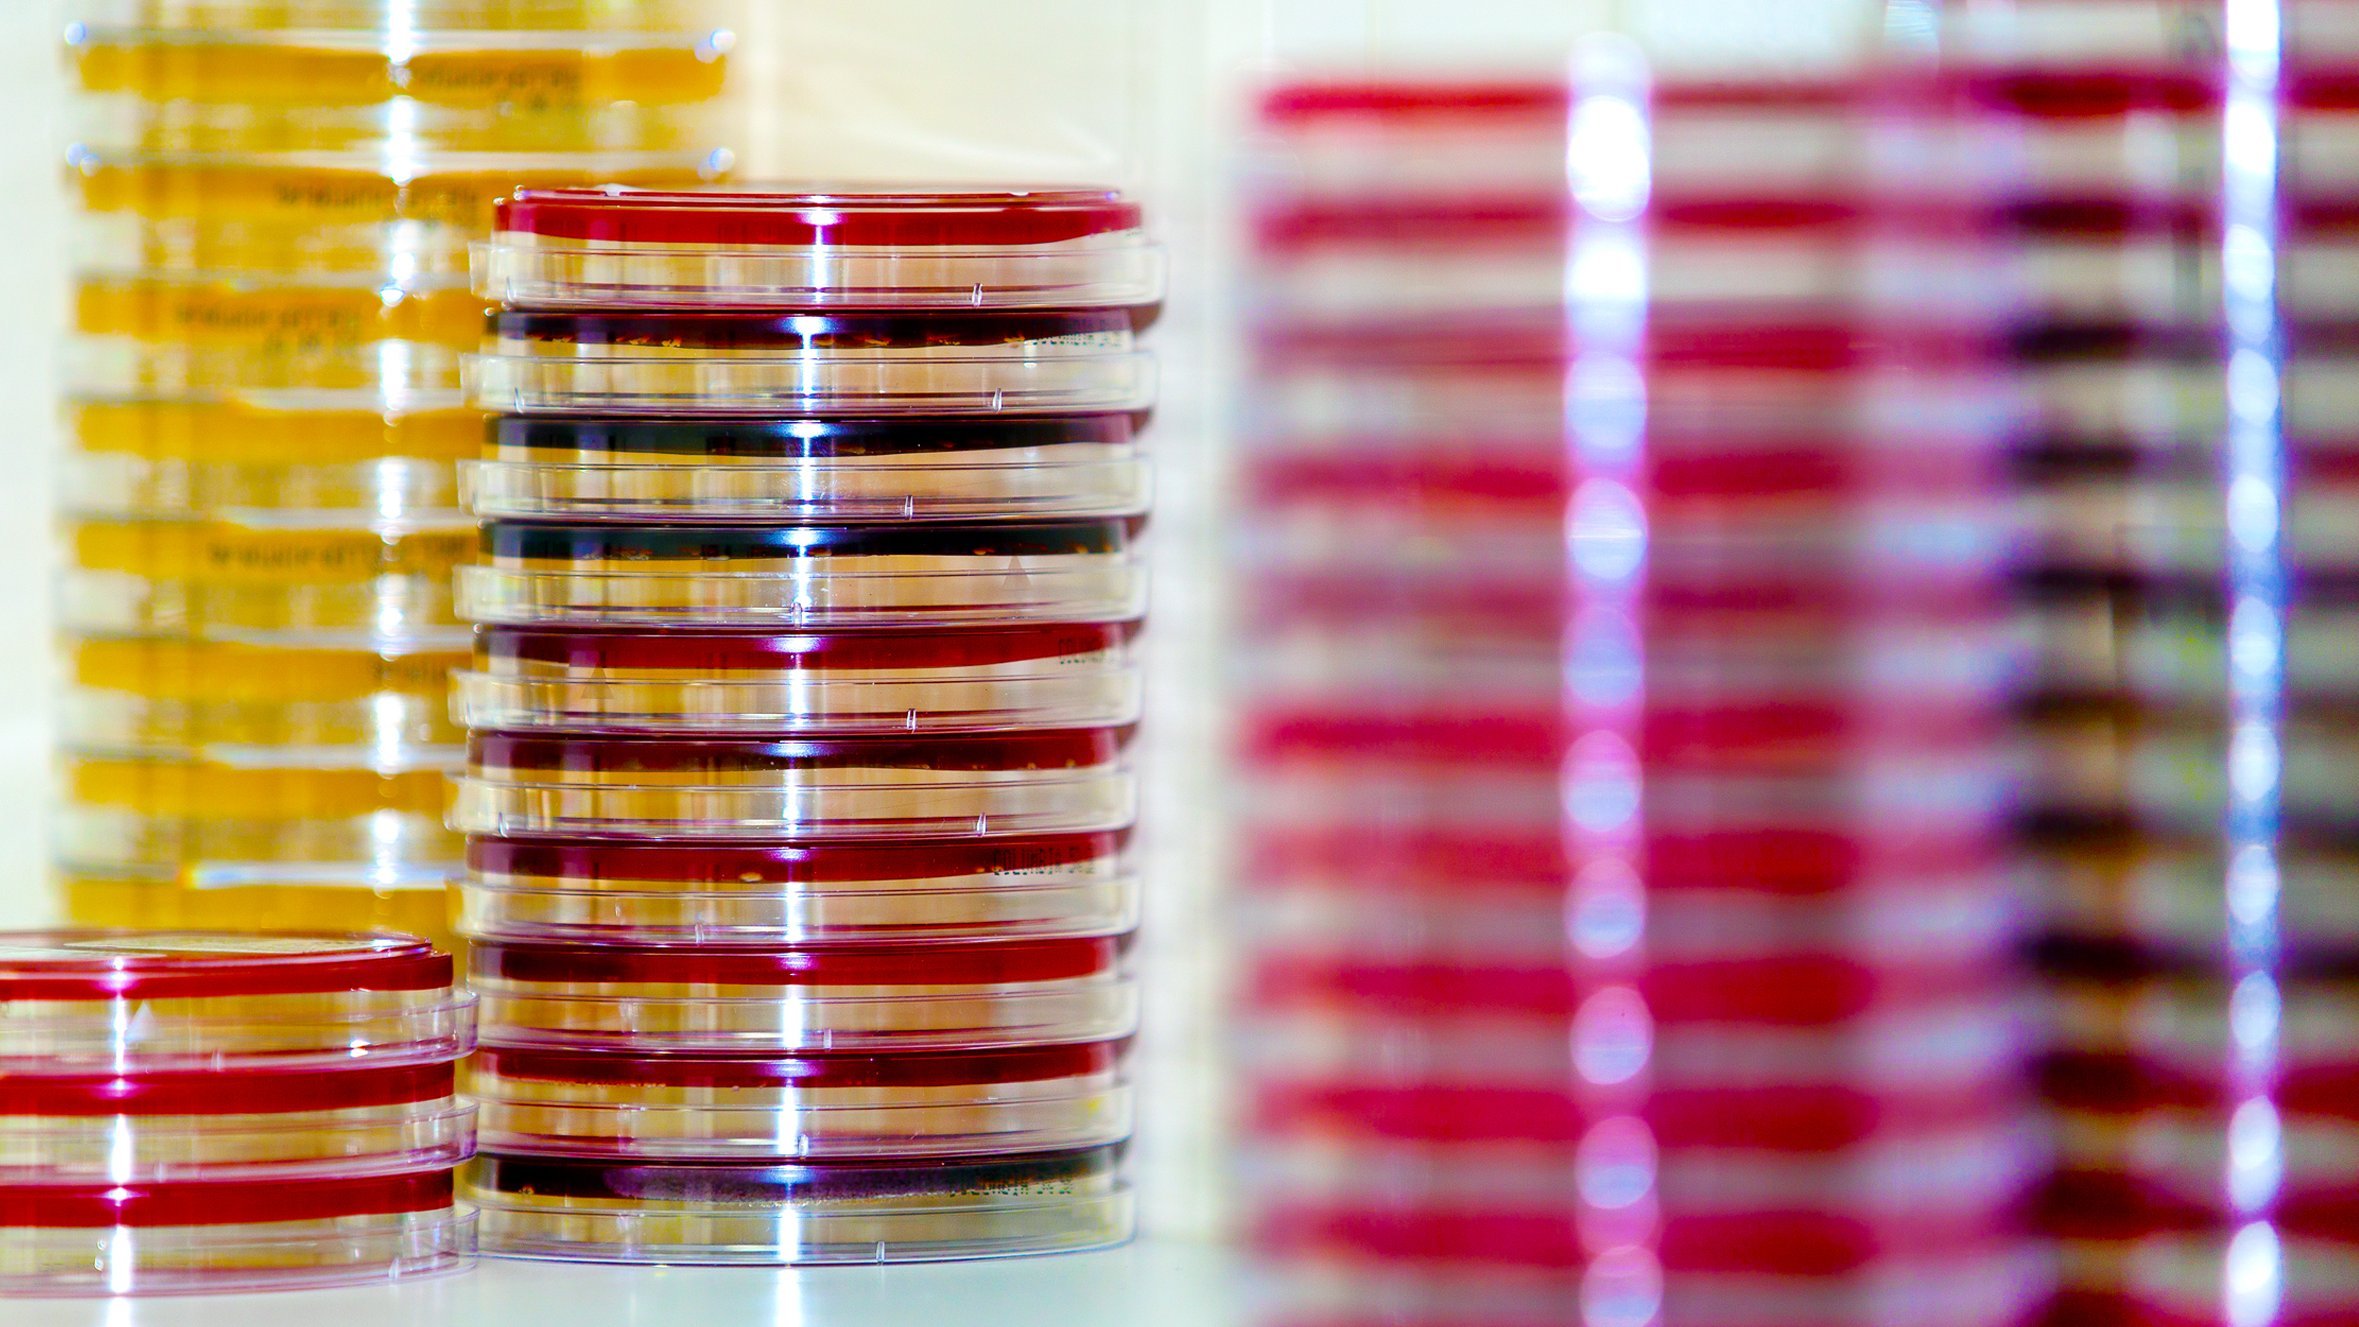

Willkommen
Wir möchten uns Ihnen kurz vorstellen.

In der Klinik für Neurochirurgie erfolgt die umfassende Behandlung des gesamten Spektrums neurochirurgischer Erkrankungen unter Einbeziehung modernster mikrochirurgischer, endoskopischer, stereotaktischer und interventioneller Behandlungsverfahren. Schwerpunkte sind u.a.
- die funktionelle Neurochirurgie,
- die Tumor- einschließlich Hypophysenchirurgie,
- die vaskuläre Neurochirurgie,
- die Schädelbasis- und
- Wirbelsäulenchirurgie,
- die Kinderneurochirurgie,
- die Schädel-Hirn-Traumatologie,
- die Schmerzchirurgie und
- neurochirurgische Intensivmedizin.
In der postoperativen Nachsorge werden individuelle Rehabilitationsmaßnahmen und ggf. onkologische oder strahlentherapeutische Weiterbehandlungen koordiniert.
Interessieren Sie sich für das aktuelle Geschehen in der Klinik? Unter Aktuelles finden Sie weitere Informationen.
Kooperationen
Innerhalb der MHH bestehen vielfache Kooperationen mit Klinken und Instituten der Medizinischen Hochschule Hannover. Weiterhin werden Kontakte zu Instituten der Leibniz-Universität Hannover und der Tierärztlichen Hochschule Hannover sowie wissenschaftliche Vernetzung mit nationalen und internationalen Kliniken und Instituten unterhalten.
So finden Sie zu uns
Ihr Aufenthalt in der MHH
Ob ambulant, stationär oder als Notfall & weitere allgemeine Informationen
Adresse, Anfahrt & Parken mit Lageplan Aktuelle Besuchsregelungen